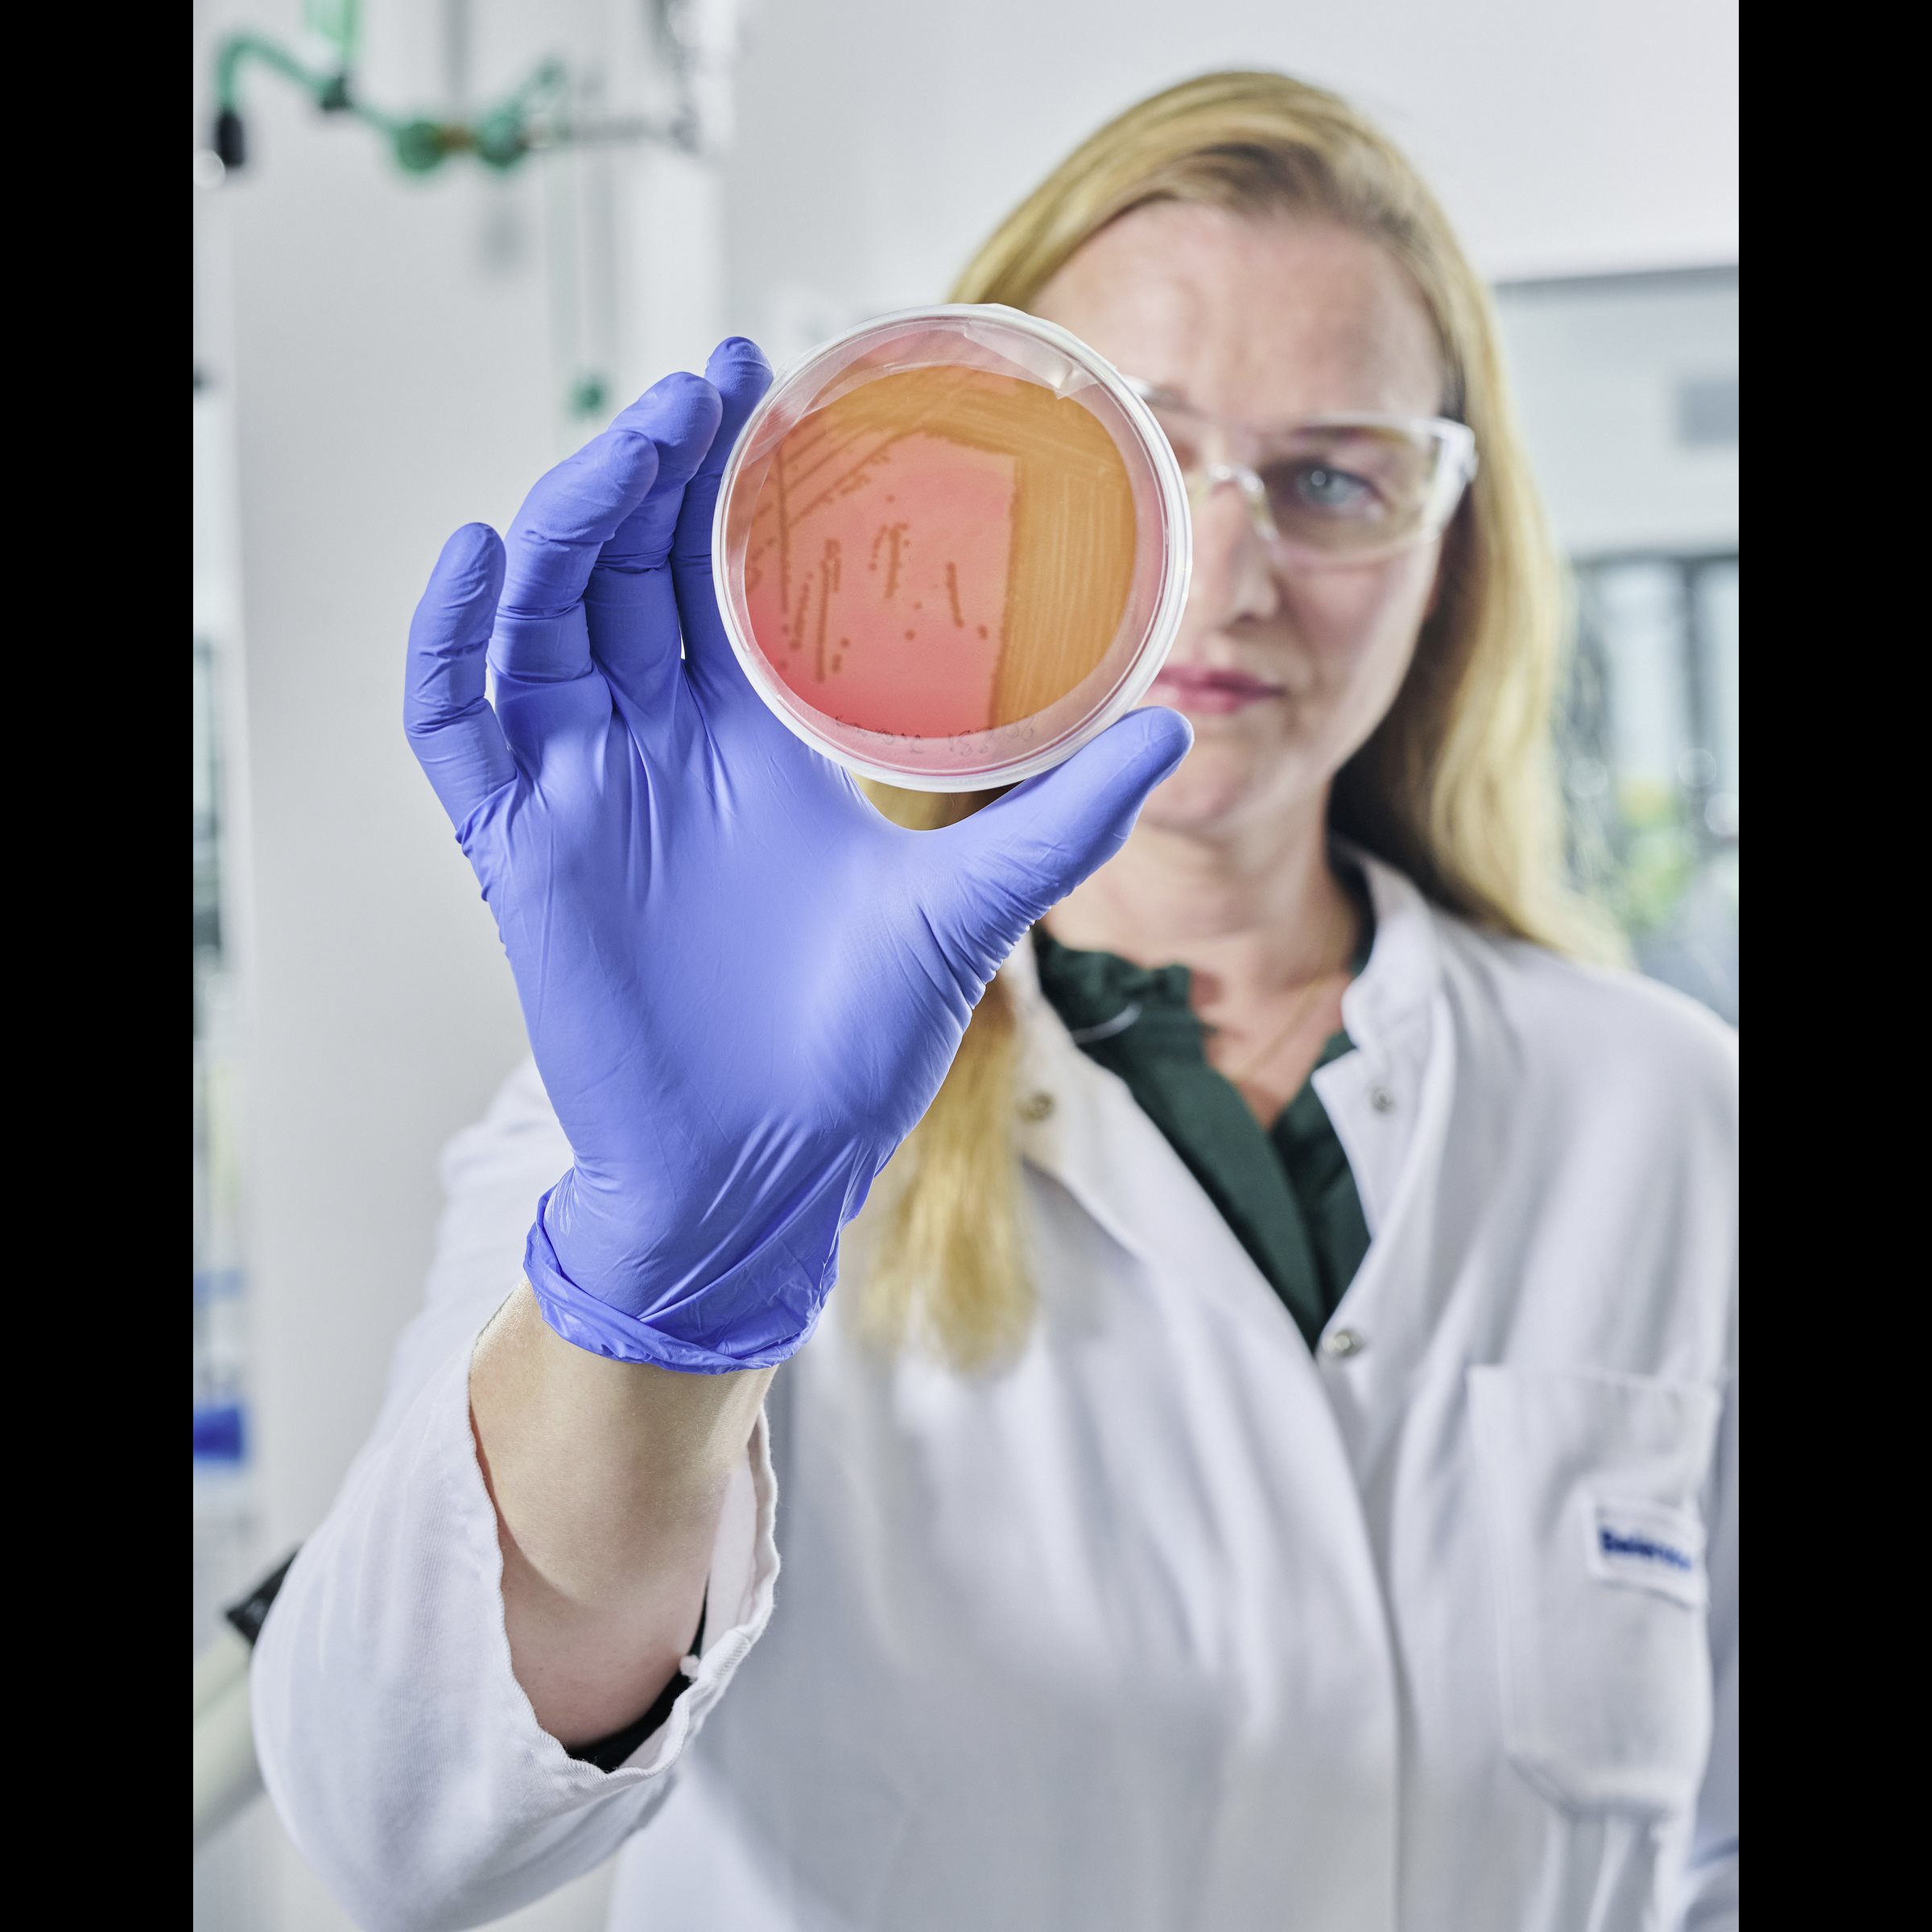

Seit über 140 Jahren entschlüsselt die Forschung und Entwicklung von Beiersdorf die komplexen Prozesse der Haut – und setzt damit wichtige Meilensteine in der Hautforschung. Unsere multidisziplinären Teams verbinden wissenschaftliche Expertise mit modernsten Technologien und entwickeln Innovationen für unterschiedlichste Hautbedürfnisse. Angetrieben von Neugier und Teamgeist entstehen so wegweisende Produktlösungen, die das Leben der Menschen weltweit berühren.